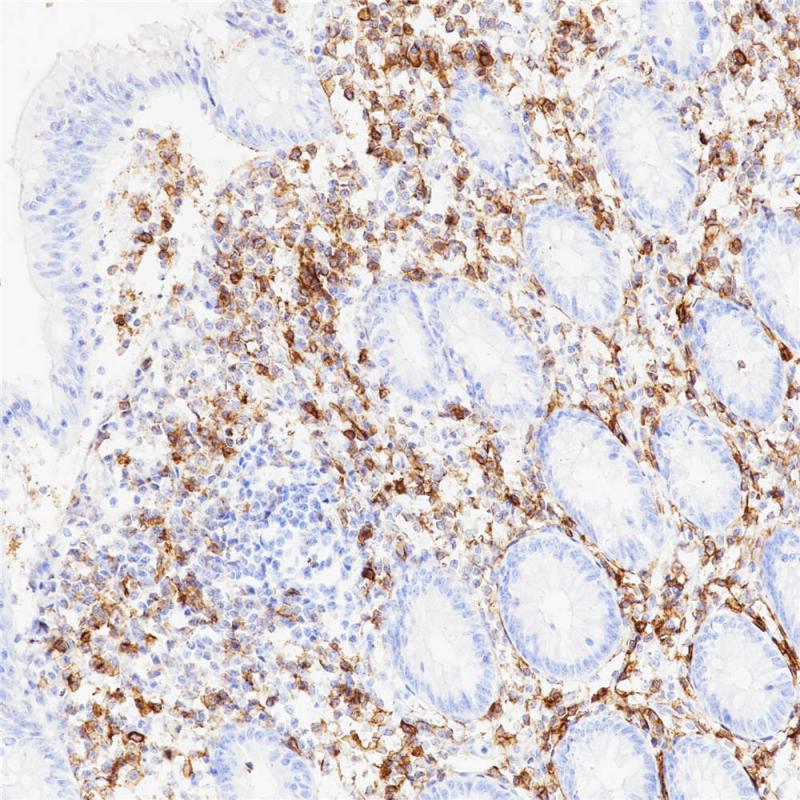
阑尾 CD38 (BP6082) 染色

产品中心
阑尾 CD38 (BP6082) 染色

扁桃体 CD38 (BP6082) 染色
CD38 重组兔单克隆抗体
CD38,也称为ADP-核糖基环化酶,合成第二信使环状ADP-核糖和烟酸-腺嘌呤二核苷酸磷酸,前者是葡萄糖诱导的胰岛素分泌的第二信使。 CD38还具有cADPr水解酶活性。 它在B和T细胞谱系的未成熟细胞上发现,但在大多数成熟的静息外周淋巴细胞上未发现。 它还存在于胸腺细胞,前B细胞,生发中心B细胞,丝裂原活化的T细胞,分泌Ig的浆细胞,单核细胞,NK细胞,骨髓中的红细胞和髓系祖细胞以及脑细胞中。CD38用于鉴定浆细胞和浆母细胞分化,并用于评估B细胞慢性淋巴细胞白血病(CLL)患者的预后。
Specifications
- 目录号
- BX50077
- 克隆号
- BP6082
- 阳性对照
- 扁桃体
- 亚细胞定位
- 细胞膜
- 组织类型
- FFPE
- 修复方式
- HIER
- 稀释比
- 1:100-1:200
- 规格
- 100μl/vial, 1ml/vial
- 用途
- RUO
Reference
1.Chini CC et al. Clin Cancer Res 20:120-30 (2014).
2.Kobayashi M et al. World J Gastroenterol 20:3597-608 (2014).


